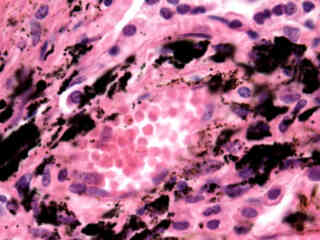
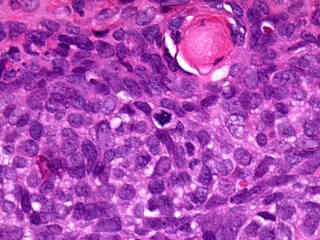
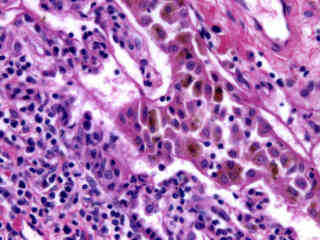
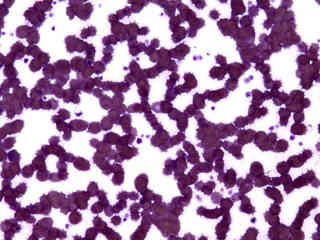
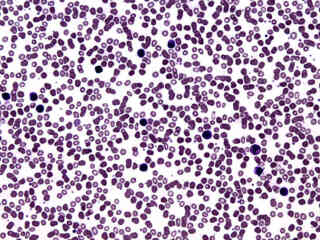
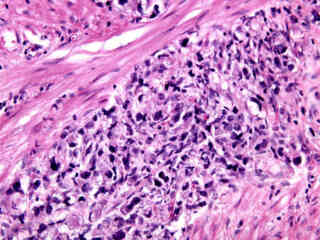
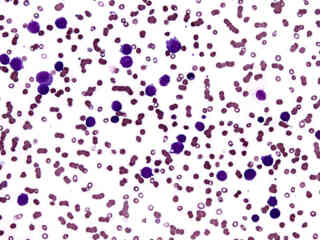
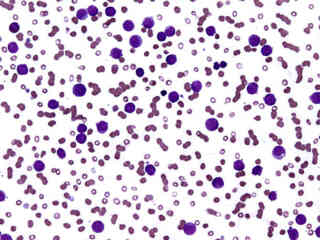
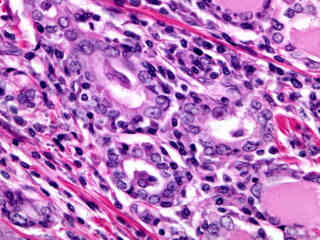
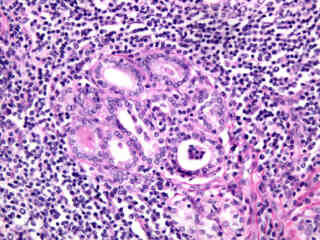
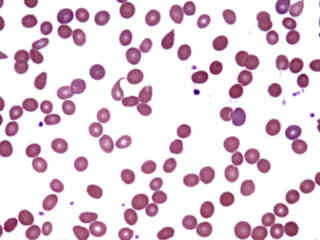
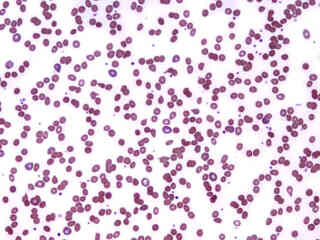
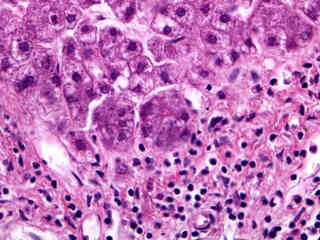
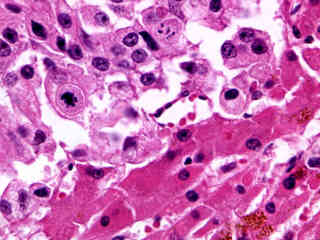
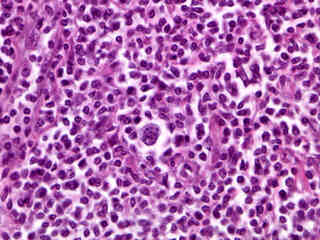
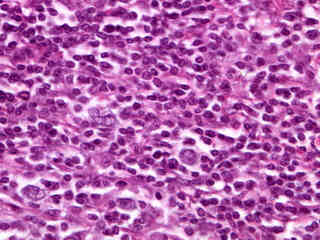
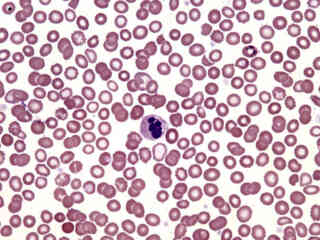
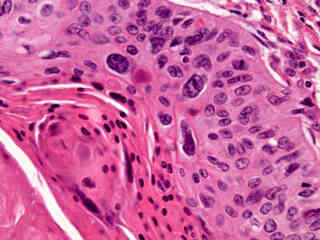
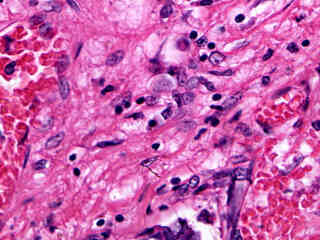
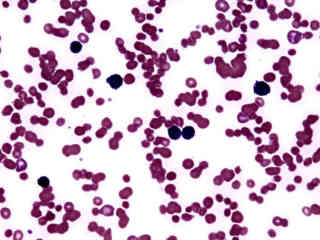
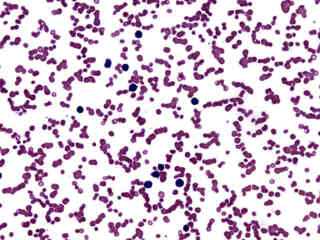
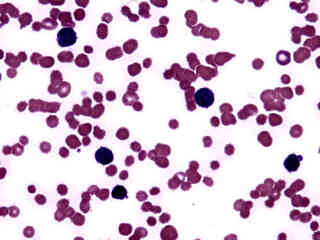
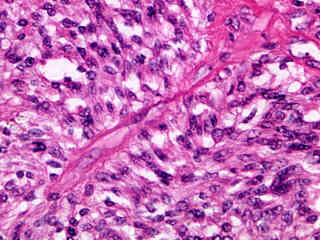
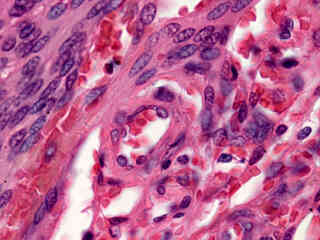
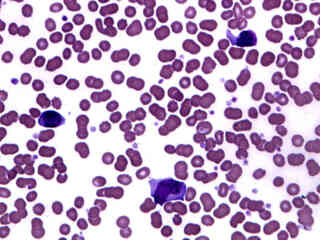
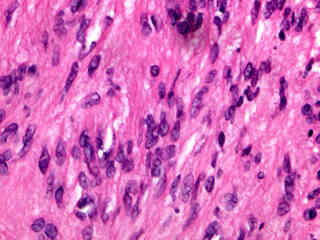
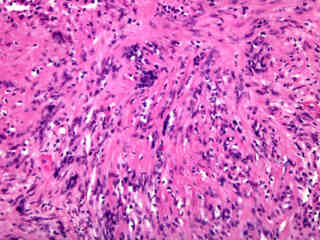
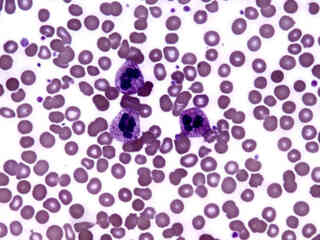
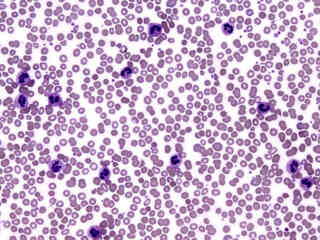
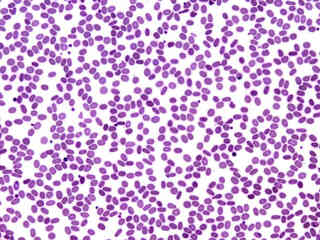
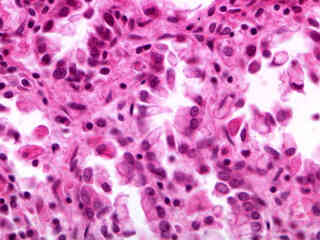
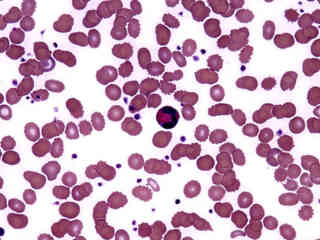
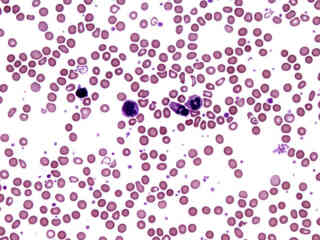
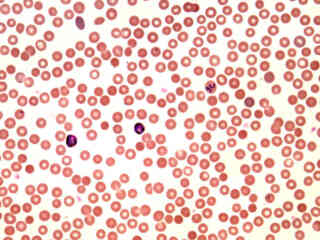
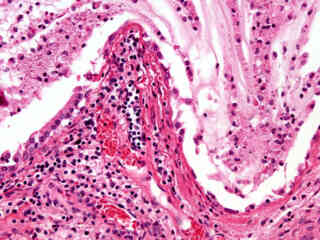
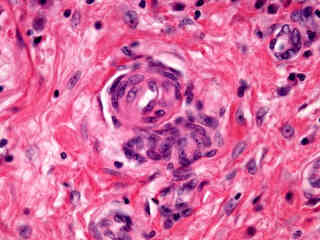
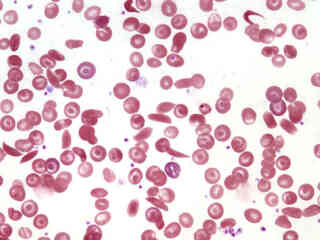
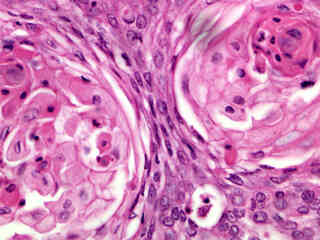
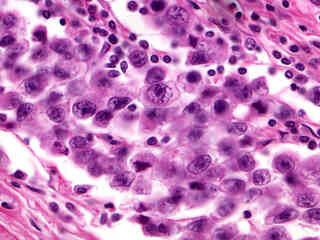
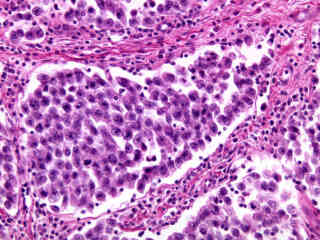
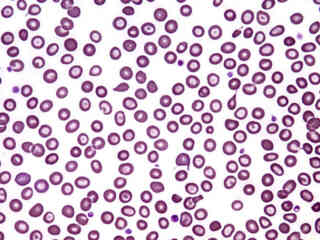
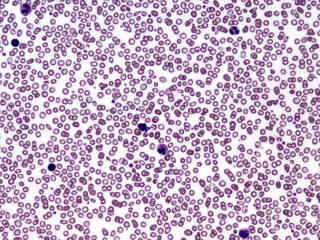
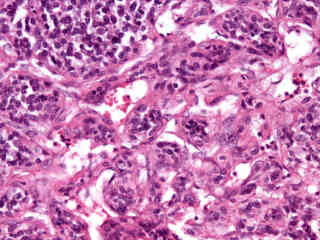
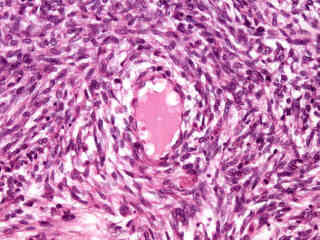

The investigation of disease in humans has, understandably, been one of the primary focal points in medicine for thousands of years. The image gallery presented in this section attempts to illustrate, through use of the brightfield microscope, many of the pathological conditions that are readily observed in stained human specimens. Each image was chosen for artistic merit, photographic quality, and content. Note that several of the images in this gallery might not depict every aspect of the pathological condition under which they are catalogued.
Aortic Atherosclerosis (Older Lesion)
Benign Prostatic Hyperplasia
Chronic Lymphocytic Leukemia
Diabetes in Kidney Tissue
Diabetes Mellitus in Pancreatic Tissue
Endometrial Adenocarcinoma
Granulocytic Leukemia (Acute)
Hematogenous Pyelonephritis
Hyperplastic Arteriosclerosis
Laryngeal Squamous Cell Carcinoma
Lung Epidermoid Carcinoma
Lymph Node Metastatic Carcinoma
Lymphocytic Leukemia (Acute)
Metastatic Carcinoma in Liver Tissue
Metastatic Carcinoma in Lung Tissue
Metastatic Melanoma in Lung Tissue
Myelomonocytic Leukemia (Acute)
Myocardial Infarction (Acute)
Myocardial Infarction (Old)
Occlusive Atherosclerosis
Plasmodium vivax Infection
Ruptured Ectopic Pregnancy
Suppurative Appendicitis (Acute)